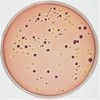

产品目录
- 试剂耗材
- 分析仪器
- 材料测试
- 生命科学
- 常用设备
- 细胞生物学
- 细胞培养皿
- 细胞培养板
- 细胞培养瓶
- 血清移液管
- 细胞过滤器
- 瓶顶过滤器
- 细胞刮铲
- 冻存管
- 冻存盒
- 血清
- 细胞培养基
- 抗生素
- 程序降温盒
- 高速2D读码仪
- 玻底培养皿
- 爬片
- 巴氏吸管
- 细胞培养基方瓶
- 培养管
- 基础培养基
- 其他试剂
- 细胞培养试剂
- 微生物检测
- 清洁度验证
- Flash快速蛋白质检测
- 其他
- 表面和液体卫生监测琼脂条
- 空气采样器
- 致病菌胶体金快速测试片
- MC-Media微生物测试片
- 活菌荧光染色快速检测系统
- 全自动取膜器
- S-Pak滤膜
- Microfil滤杯和滤膜组合套装
- EFFU无菌滤杯
- 真空泵
- 微生物过滤系统
- Milliflex Plus 全自动过滤系统
- 生物指示剂
- 液体预制培养基
- 干粉培养基
- 乳酸菌检测相关培养基
- 梭菌检测相关培养基
- 军团菌检测相关培养基
- 芽孢杆菌检测相关培养基
- 耶尔森氏菌检测相关培养基
- 弧菌检测相关培养基
- 金黄色葡萄球菌相关培养基
- 李斯特菌检测相关培养基
- 沙门氏菌和志贺菌检测相关培养基
- 大肠菌相关检测培养基
- 酵母菌检测相关培养基
- 菌落总数检测相关培养基
- 取样片和棉签套装
- 无菌模拟灌装培养基